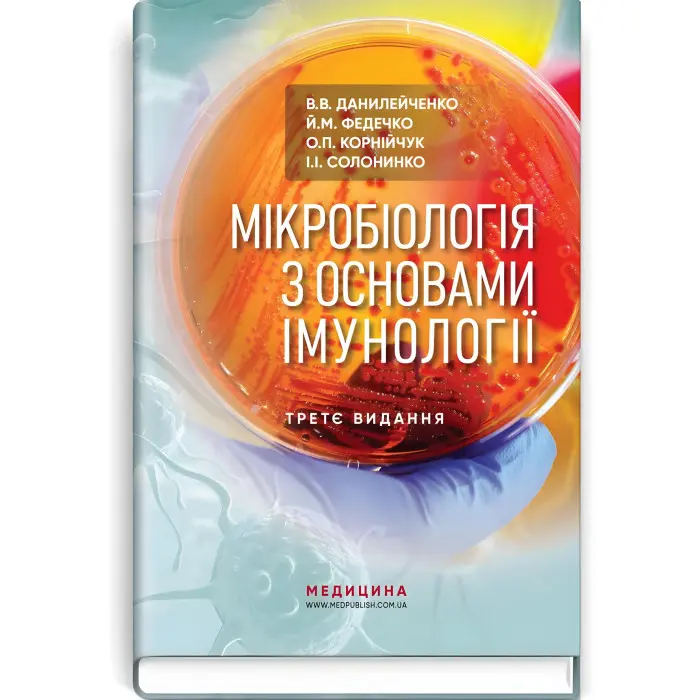
Мікробіологія з основами імунології: підручник / В.В. Данилейченко, Й.М. Федечко, О.П. Корнійчук, І.І. Солонинко. — 3-є видання

Опис Мікробіологія з основами імунології: підручник / В.В. Данилейченко, Й.М. Федечко, О.П. Корнійчук, І.І. Солонинко. — 3-є видання
"Мікробіологія з основами імунології: підручник" (3-є видання) — це оновлене та розширене видання фундаментального навчального посібника, призначеного для студентів медичних і біологічних факультетів. Автори В.В. Данилейченко, Й.М. Федечко, О.П. Корнійчук та І.І. Солонинко представляють всебічний огляд ключових понять мікробіології та імунології, з особливою увагою до патогенезу, діагностики та профілактики інфекційних захворювань.
Основні характеристики книги:
-
Мікробіологія: Підручник охоплює основні положення загальної мікробіології, включаючи будову, функції та класифікацію мікроорганізмів. Автори докладно розглядають біологічні властивості бактерій, вірусів, грибків та інших мікроорганізмів, які взаємодіють з людським організмом, і їх роль у розвитку інфекційних хвороб.
-
Основи імунології: Окрім мікробіології, у підручнику детально розкрито механізми імунної системи. Розглянуто процеси імунного захисту, зокрема вроджений і набутий імунітет, а також механізми розпізнавання та знищення патогенів імунною системою.
-
Інфекційні процеси та їх діагностика: У книзі описано механізми патогенезу різних мікробних інфекцій, їх вплив на організм людини, а також методи лабораторної діагностики, які використовуються для виявлення патогенів. Читач дізнається про сучасні підходи до ідентифікації інфекційних агентів і методи профілактики інфекційних хвороб.
-
Антибіотики та антимікробна терапія: Окремі розділи присвячено опису антимікробних препаратів, їх класифікації, механізмам дії та розвитку резистентності у мікроорганізмів.
Переваги 3-го видання:
-
Оновлені матеріали: Третє видання підручника включає останні досягнення в галузі мікробіології та імунології, зокрема нові дослідження у галузі молекулярної мікробіології та розвитку вакцин.
-
Практична спрямованість: У підручнику наведено конкретні приклади клінічних випадків та лабораторних досліджень, що робить матеріал максимально наближеним до реальної практики. Це дозволяє студентам краще підготуватися до роботи у медичних закладах.
-
Доступність викладу: Підручник вирізняється логічною структурою та чітким стилем викладу, що дозволяє легко засвоювати складні матеріали як студентам, так і лікарям, які хочуть оновити свої знання.
Для кого призначена книга:
-
Студенти медичних і біологічних спеціальностей: Це видання стане важливим ресурсом для тих, хто навчається на лікарів, мікробіологів, біологів та інших спеціалістів у галузі охорони здоров'я.
-
Практикуючі лікарі та фахівці у галузі лабораторної діагностики: Підручник допоможе в оновленні знань про сучасні методи діагностики інфекцій та лікування мікробних захворювань.
-
Дослідники: Фахівці, які працюють у галузі мікробіології та імунології, знайдуть у книзі актуальні наукові дані для своїх досліджень.
Основні теми підручника:
- Вступ до мікробіології: основи, класифікація та функції мікроорганізмів.
- Бактеріологія: структура і життєвий цикл бактерій.
- Вірусологія: різновиди вірусів і методи боротьби з ними.
- Мікологія та паразитологія: грибкові та паразитарні інфекції.
- Основи імунітету: клітинні і гуморальні механізми захисту організму.
- Лабораторна діагностика інфекційних захворювань.
- Антимікробні засоби та резистентність.
"Мікробіологія з основами імунології" — це незамінний навчальний ресурс, який поєднує в собі теоретичні знання та практичні аспекти, необхідні для глибокого розуміння мікробіології та імунології.
Основні характеристики Мікробіологія з основами імунології: підручник / В.В. Данилейченко, Й.М. Федечко, О.П. Корнійчук, І.І. Солонинко. — 3-є видання
Відгуки про Мікробіологія з основами імунології: підручник / В.В. Данилейченко, Й.М. Федечко, О.П. Корнійчук, І.І. Солонинко. — 3-є видання
Немає відгуків про цей товар.
Питання та відповіді (FAQ) Мікробіологія з основами імунології: підручник / В.В. Данилейченко, Й.М. Федечко, О.П. Корнійчук, І.І. Солонинко. — 3-є видання